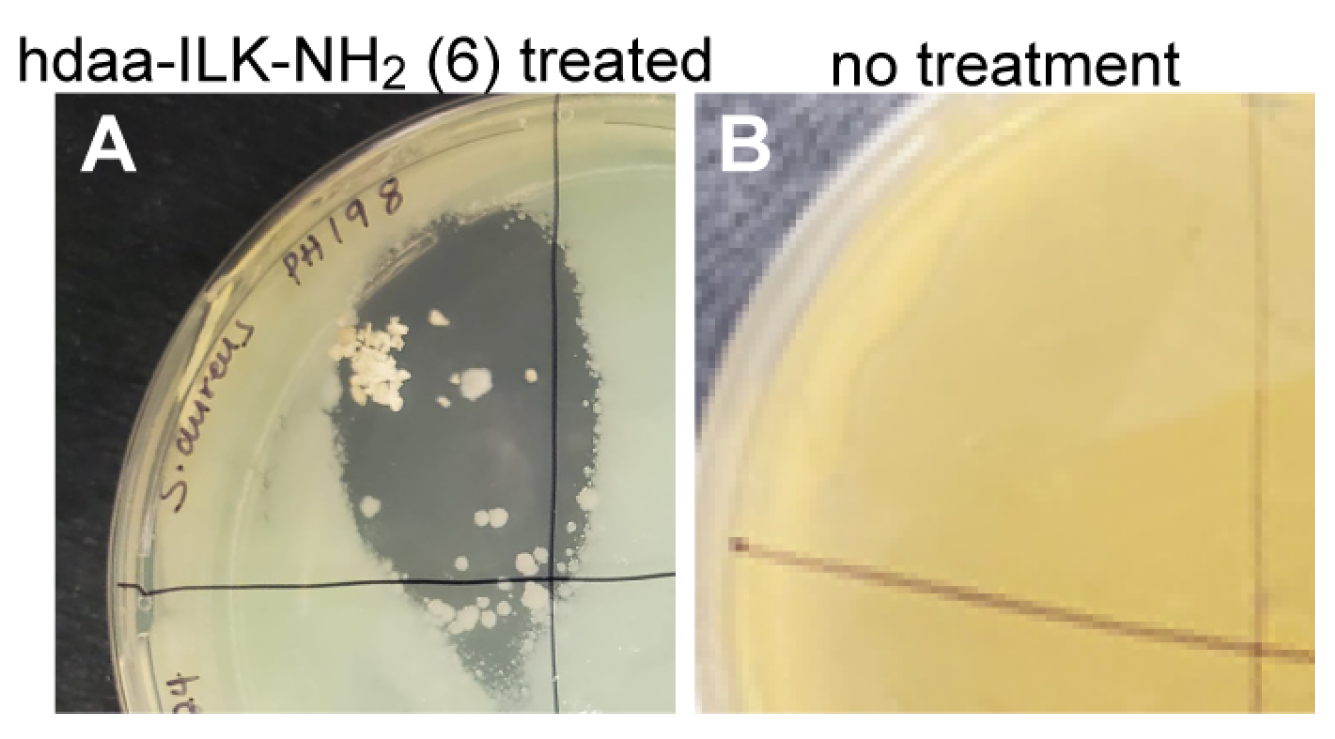

Molecular Modification of Queen Bee Acid and 10-Hydroxydecanoic Acid with Specific Tripeptides: Rational Design, Organic Synthesis, and Assessment for Prohealing and Antimicrobial Hydrogel Properties
Abstract
1. Introduction
2. Results and Discussion
2.1. Rational Design and Solid Phase Organic Synthesis of Novel Amphiphiles Covalently Modified from hda, hdaa, or Other Hydroxy Fatty Acids with Specific Tripeptides
2.2. NMR Data Verified the Structures of the Molecules Synthesized
2.3. Collision Induced Dissociation MS/MS Spectral Fragmentation Ions Verified Structures of the Molecules Synthesized
2.4. Prohealing Relevant Hydrogelability of Amphiphiles Covalently Modified from hda, hdaa, or Other hfa with Specific Tripeptides
2.5. Rheological and Shear-Thinning Properties of Hydrogels Self-Assembled from the Selected Novel Amphiphiles
2.6. Determination of Gelation-Related Fibrous Structures Using Field Emission Scanning or Transmission Electronic Microscopy
2.7. The Evaluation of Antibacterial Activity
3. Materials and Methods
3.1. Materials
3.2. Synthesis and Structural Analysis of an Amphiphile Modified from a Hydroxyl Fatty Acid with a Tripeptide via Peptide Bonding
3.3. Instrumental Molecular Analysis
3.3.1. LC–MS/MS Method
3.3.2. NMR Method
3.4. Hydrogelation Tests
3.4.1. Hydrogel Preparation and Test
3.4.2. Sterile Conditions
3.5. Rheological Test Procedures
3.6. Procedures for Field Emission Scanning or Transmission Electronic Microscopy
3.7. Antibacterial Activity Assessment by Kirby–Bauer Disc Diffusion Method
3.8. Statistical Analysis
4. Conclusions
5. Patents
Supplementary Materials
Author Contributions
Funding
Institutional Review Board Statement
Informed Consent Statement
Data Availability Statement
Acknowledgments
Conflicts of Interest
References
- Angioi, R.; Morrin, A.; White, B. The Rediscovery of Honey for Skin Repair: Recent Advances in Mechanisms for Honey-Mediated Wound Healing and Scaffolded Application Techniques. Appl. Sci. 2021, 11, 5192. [Google Scholar] [CrossRef]
- Isidorow, W.; Witkowski, S.; Iwaniuk, P.; Zambrzycka, M. Royal Jelly Aliphatic Acids Contribute to Antimicrobial Activity of Honey. J. Apic. Sci. 2018, 62, 111–123. [Google Scholar] [CrossRef]
- Civelek, I. Biological activities of royal jelly: A mini-review. Anatol. J. Biol. 2022, 1, 1–8. [Google Scholar]
- Pasupuleti, V.R.; Sammugam, L.; Ramesh, N.; Gan, S.H. Honey, Propolis, and Royal Jelly: A Comprehensive Review of Their Biological Actions and Health Benefits. Oxid. Med. Cell. Longev. 2017, 2017, 1259510. [Google Scholar] [CrossRef]
- Chen, Y.F.; Wang, K.; Zhang, Y.Z.; Zheng, Y.F.; Hu, F.L. In Vitro Anti-Inflammatory Effects of Three Fatty Acids from Royal Jelly. Mediat. Inflamm. 2016, 2016, 3583684. [Google Scholar] [CrossRef]
- Yang, X.Y.; Yang, D.S.; Wei, Z.; Wang, J.M.; Li, C.Y.; Hui, Y.; Lei, K.F.; Chen, X.F.; Shen, N.H.; Jin, L.Q.; et al. 10-Hydroxy-2-decenoic acid from Royal jelly: A potential medicine for RA. J. Ethnopharmacol. 2010, 128, 314–321. [Google Scholar] [CrossRef]
- Visavadia, B.G.; Honeysett, J.; Danford, M. Manuka honey dressing: An effective treatment for chronic wound infections. Br. J. Oral. Maxillofac. Surg. 2008, 46, 696–697. [Google Scholar] [CrossRef]
- Gethin, G.; Cowman, S. Case series of use of Manuka honey in leg ulceration. Int. Wound J. 2005, 2, 10–15. [Google Scholar] [CrossRef]
- Al-Waili, N.; Al-Ghamdi, A.; Ansari, M.J.; Al-Attal, Y.; Salom, K. Synergistic effects of honey and propolis toward drug multi-resistant Staphylococcus aureus, Escherichia coli and Candida albicans isolates in single and polymicrobial cultures. Int. J. Med. Sci. 2012, 9, 793–800. [Google Scholar] [CrossRef]
- Simon, A.; Sofka, K.; Wiszniewsky, G.; Blaser, G.; Bode, U.; Fleischhack, G. Wound care with antibacterial honey (Medihoney) in pediatric hematology-oncology. Support. Care Cancer 2006, 14, 91–97. [Google Scholar] [CrossRef]
- Yaghoobi, R.; Kazerouni, A.; Kazerouni, O. Evidence for Clinical Use of Honey in Wound Healing as an Anti-bacterial, Anti-inflammatory Anti-oxidant and Anti-viral Agent: A Review. Jundishapur J. Nat. Pharm. Prod. 2013, 8, 100–104. [Google Scholar] [CrossRef] [PubMed]
- Norman, G.; Christie, J.; Liu, Z.; Westby, M.J.; Jefferies, J.M.; Hudson, T.; Edwards, J.; Mohapatra, D.P.; Hassan, I.A.; Dumville, J.C. Antiseptics for burns. Cochrane Database Syst. Rev. 2017, 7, CD011821. [Google Scholar] [CrossRef] [PubMed]
- Jull, A.B.; Cullum, N.; Dumville, J.C.; Westby, M.J.; Deshpande, S.; Walker, N. Honey as a topical treatment for wounds. Cochrane Database Syst. Rev. 2015, 2015, CD005083. [Google Scholar] [CrossRef] [PubMed]
- Astrada, A.; Nakagami, G.; Jais, S.; Sanada, H. Successful treatment of a diabetic foot ulcer with exposed bone using Trigona honey: A case study. J. Wound Care 2019, 28, S4–S8. [Google Scholar] [CrossRef]
- Alam, F.; Islam, M.A.; Gan, S.H.; Khalil, M.I. Honey: A potential therapeutic agent for managing diabetic wounds. Evid. Based Complement. Altern. Med. 2014, 2014, 169130. [Google Scholar] [CrossRef]
- Karimi, Z.; Behnammoghadam, M.; Rafiei, H.; Abdi, N.; Zoladl, M.; Talebianpoor, M.S.; Arya, A.; Khastavaneh, M. Impact of olive oil and honey on healing of diabetic foot: A randomized controlled trial. Clin. Cosmet. Investig. Dermatol. 2019, 12, 347–354. [Google Scholar] [CrossRef]
- Yang, Y.C.; Chou, W.M.; Widowati, D.A.; Lin, I.P.; Peng, C.C. 10-hydroxy-2-decenoic acid of royal jelly exhibits bactericide and anti-inflammatory activity in human colon cancer cells. BMC Complement. Altern. Med. 2018, 18, 202. [Google Scholar] [CrossRef]
- Han, L.; Zhang, M.; Li, F.; Su, J.; Wang, R.; Li, G.; Yang, X. 10-hydroxy-2-decenoic acid alleviates lipopolysaccharide-induced intestinal mucosal injury through anti-inflammatory, antioxidant, and gut microbiota modulation activities in chickens. Front. Microbiol. 2023, 14, 1285299. [Google Scholar] [CrossRef]
- Fan, P.; Sha, F.; Ma, C.; Wei, Q.; Zhou, Y.; Shi, J.; Fu, J.; Zhang, L.; Han, B.; Li, J. 10-Hydroxydec-2-Enoic Acid Reduces Hydroxyl Free Radical-Induced Damage to Vascular Smooth Muscle Cells by Rescuing Protein and Energy Metabolism. Front. Nutr. 2022, 9, 873892. [Google Scholar] [CrossRef]
- Zheng, J.; Lai, W.; Zhu, G.; Wan, M.; Chen, J.; Tai, Y.; Lu, C. 10-Hydroxy-2-decenoic acid prevents ultraviolet A-induced damage and matrix metalloproteinases expression in human dermal fibroblasts. J. Eur. Acad. Dermatol. Venereol. 2013, 27, 1269–1277. [Google Scholar] [CrossRef]
- Hattori, N.; Nomoto, H.; Fukumitsu, H.; Mishima, S.; Furukawa, S. Royal jelly and its unique fatty acid, 10-hydroxy-trans-2-decenoic acid, promote neurogenesis by neural stem/progenitor cells in vitro. Biomed. Res. 2007, 28, 261–266. [Google Scholar] [CrossRef] [PubMed]
- You, M.; Miao, Z.; Pan, Y.; Hu, F. Trans-10-hydroxy-2-decenoic acid alleviates LPS-induced blood-brain barrier dysfunction by activating the AMPK/PI3K/AKT pathway. Eur. J. Pharmacol. 2019, 865, 172736. [Google Scholar] [CrossRef] [PubMed]
- Fan, P.; Han, B.; Hu, H.; Wei, Q.; Zhang, X.; Meng, L.; Nie, J.; Tang, X.; Tian, X.; Zhang, L.; et al. Proteome of thymus and spleen reveals that 10-hydroxydec-2-enoic acid could enhance immunity in mice. Expert Opin. Ther. Targets 2020, 24, 267–279. [Google Scholar] [CrossRef] [PubMed]
- Sugiyama, T.; Takahashi, K.; Tokoro, S.; Gotou, T.; Neri, P.; Mori, H. Inhibitory effect of 10-hydroxy-trans-2-decenoic acid on LPS-induced IL-6 production via reducing IkappaB-zeta expression. Innate Immun. 2012, 18, 429–437. [Google Scholar] [CrossRef]
- Wang, J.G.; Ruan, J.; Li, C.Y.; Wang, J.M.; Li, Y.; Zhai, W.T.; Zhang, W.; Ye, H.; Shen, N.H.; Lei, K.F.; et al. Connective tissue growth factor, a regulator related with 10-hydroxy-2-decenoic acid down-regulate MMPs in rheumatoid arthritis. Rheumatol. Int. 2012, 32, 2791–2799. [Google Scholar] [CrossRef]
- You, M.; Miao, Z.; Sienkiewicz, O.; Jiang, X.; Zhao, X.; Hu, F. 10-Hydroxydecanoic acid inhibits LPS-induced inflammation by targeting p53 in microglial cells. Int. Immunopharmacol. 2020, 84, 106501. [Google Scholar] [CrossRef]
- Kumar, P.; Singh, S.K.; Handa, V.; Kathuria, H. Oleic Acid Nanovesicles of Minoxidil for Enhanced Follicular Delivery. Medicines 2018, 5, 103. [Google Scholar] [CrossRef]
- Takahashi, K.; Sugiyama, T.; Tokoro, S.; Neri, P.; Mori, H. Inhibitory effect of 10-hydroxydecanoic acid on lipopolysaccharide-induced nitric oxide production via translational downregulation of interferon regulatory factor-1 in RAW264 murine macrophages. Biomed. Res. 2013, 34, 205–214. [Google Scholar] [CrossRef]
- Leung, R.; Ho, A.; Chan, J.; Choy, D.; Lai, C.K. Royal jelly consumption and hypersensitivity in the community. Clin. Exp. Allergy 1997, 27, 333–336. [Google Scholar] [CrossRef]
- Takahama, H.; Shimazu, T. Food-induced anaphylaxis caused by ingestion of royal jelly. J. Dermatol. 2006, 33, 424–426. [Google Scholar] [CrossRef]
- Yasin, S.N.N.; Said, Z.; Halib, N.; Rahman, Z.A.; Mokhzani, N.I. Polymer-Based Hydrogel Loaded with Honey in Drug Delivery System for Wound Healing Applications. Polymers 2023, 15, 3085. [Google Scholar] [CrossRef] [PubMed]
- Tan, D.; Zhu, W.; Liu, L.; Pan, Y. In situ formed scaffold with royal jelly-derived extracellular vesicles for wound healing. Theranostics 2023, 13, 2811–2824. [Google Scholar] [CrossRef] [PubMed]
- Jaldin-Crespo, L.; Silva, N.; Martinez, J. Nanomaterials Based on Honey and Propolis for Wound Healing-A Mini-Review. Nanomaterials 2022, 12, 4409. [Google Scholar] [CrossRef] [PubMed]
- Bahari, N.; Hashim, N.; Md Akim, A.; Maringgal, B. Recent Advances in Honey-Based Nanoparticles for Wound Dressing: A Review. Nanomaterials 2022, 12, 2560. [Google Scholar] [CrossRef]
- Brem, H.; Tomic-Canic, M.; Entero, H.; Hanflik, A.M.; Wang, V.M.; Fallon, J.T.; Ehrlich, H.P. The synergism of age and db/db genotype impairs wound healing. Exp. Gerontol. 2007, 42, 523–531. [Google Scholar] [CrossRef]
- Liu, L.; Marti, G.P.; Wei, X.; Zhang, X.; Zhang, H.; Liu, Y.V.; Nastai, M.; Semenza, G.L.; Harmon, J.W. Age-dependent impairment of HIF-1alpha expression in diabetic mice: Correction with electroporation-facilitated gene therapy increases wound healing, angiogenesis, and circulating angiogenic cells. J. Cell. Physiol. 2008, 217, 319–327. [Google Scholar] [CrossRef]
- Gosain, A.; DiPietro, L.A. Aging and wound healing. World J. Surg. 2004, 28, 321–326. [Google Scholar] [CrossRef]
- Han, G.; Ceilley, R. Chronic Wound Healing: A Review of Current Management and Treatments. Adv. Ther. 2017, 34, 599–610. [Google Scholar] [CrossRef]
- Kirker, K.R.; Luo, Y.; Nielson, J.H.; Shelby, J.; Prestwich, G.D. Glycosaminoglycan hydrogel films as bio-interactive dressings for wound healing. Biomaterials 2002, 23, 3661–3671. [Google Scholar] [CrossRef]
- Boucard, N.; Viton, C.; Agay, D.; Mari, E.; Roger, T.; Chancerelle, Y.; Domard, A. The use of physical hydrogels of chitosan for skin regeneration following third-degree burns. Biomaterials 2007, 28, 3478–3488. [Google Scholar] [CrossRef]
- Kiyozumi, T.; Kanatani, Y.; Ishihara, M.; Saitoh, D.; Shimizu, J.; Yura, H.; Suzuki, S.; Okada, Y.; Kikuchi, M. The effect of chitosan hydrogel containing DMEM/F12 medium on full-thickness skin defects after deep dermal burn. Burns 2007, 33, 642–648. [Google Scholar] [CrossRef] [PubMed]
- Kim, K.L.; Han, D.K.; Park, K.; Song, S.H.; Kim, J.Y.; Kim, J.M.; Ki, H.Y.; Yie, S.W.; Roh, C.R.; Jeon, E.S.; et al. Enhanced dermal wound neovascularization by targeted delivery of endothelial progenitor cells using an RGD-g-PLLA scaffold. Biomaterials 2009, 30, 3742–3748. [Google Scholar] [CrossRef] [PubMed]
- Madsen, J.; Armes, S.P.; Bertal, K.; Lomas, H.; Macneil, S.; Lewis, A.L. Biocompatible wound dressings based on chemically degradable triblock copolymer hydrogels. Biomacromolecules 2008, 9, 2265–2275. [Google Scholar] [CrossRef] [PubMed]
- Shepherd, J.; Sarker, P.; Rimmer, S.; Swanson, L.; MacNeil, S.; Douglas, I. Hyperbranched poly(NIPAM) polymers modified with antibiotics for the reduction of bacterial burden in infected human tissue engineered skin. Biomaterials 2011, 32, 258–267. [Google Scholar] [CrossRef]
- Balakrishnan, B.; Mohanty, M.; Umashankar, P.R.; Jayakrishnan, A. Evaluation of an in situ forming hydrogel wound dressing based on oxidized alginate and gelatin. Biomaterials 2005, 26, 6335–6342. [Google Scholar] [CrossRef]
- Anjum, A.; Sim, C.H.; Ng, S.F. Hydrogels Containing Antibiofilm and Antimicrobial Agents Beneficial for Biofilm-Associated Wound Infection: Formulation Characterizations and In vitro Study. AAPS PharmSciTech 2018, 19, 1219–1230. [Google Scholar] [CrossRef]
- Ghomi, E.R.; Khalili, S.; Khorasani, S.N.; Neisiany, R.S.; Ramakrishna, S. Wound dressings: Current advances and future directions. J. Appl. Polym. Sci. 2019, 136, 47738. [Google Scholar] [CrossRef]
- Antimicrobial Resistance Information from FDA. 2024. Available online: https://www.fda.gov/emergency-preparedness-and-response/mcm-issues/antimicrobial-resistance-information-fda (accessed on 1 January 2025).
- Ronco, T.; Aragao, M.F.; Svenningsen, S.; Christensen, J.B.; Permin, A.; Saaby, L.; Bionda, N.; Lantz, E.E.; Olsen, R.H. Efficacy of a novel antimicrobial hydrogel for eradication of Staphylococcus epidermidis, Staphylococcus aureus and Cutibacterium acnes from preformed biofilm and treatment performance in an in vivo MRSA wound model. JAC Antimicrob. Resist. 2021, 3, dlab108. [Google Scholar] [CrossRef]
- Goswami, A.G.; Basu, S.; Banerjee, T.; Shukla, V.K. Biofilm and wound healing: From bench to bedside. Eur. J. Med. Res. 2023, 28, 157. [Google Scholar] [CrossRef]
- Nakagami, G.; Schultz, G.; Gibson, D.J.; Phillips, P.; Kitamura, A.; Minematsu, T.; Miyagaki, T.; Hayashi, A.; Sasaki, S.; Sugama, J.; et al. Biofilm detection by wound blotting can predict slough development in pressure ulcers: A prospective observational study. Wound Repair. Regen. 2017, 25, 131–138. [Google Scholar] [CrossRef]
- Maher, E.; Anokhin, A. Bacterial Skin and Soft Tissue Infections in Older Adults. Clin. Geriatr. Med. 2024, 40, 117–130. [Google Scholar] [CrossRef] [PubMed]
- Mangram, A.J.; Horan, T.C.; Pearson, M.L.; Silver, L.C.; Jarvis, W.R. Guideline for Prevention of Surgical Site Infection, 1999. Centers for Disease Control and Prevention (CDC) Hospital Infection Control Practices Advisory Committee. Am. J. Infect. Control. 1999, 27, 97–132; quiz 133–134; discussion 196. [Google Scholar] [CrossRef] [PubMed]
- Lee, J.; Singletary, R.; Schmader, K.; Anderson, D.J.; Bolognesi, M.; Kaye, K.S. Surgical site infection in the elderly following orthopaedic surgery. Risk factors and outcomes. J. Bone Jt. Surg. Am. 2006, 88, 1705–1712. [Google Scholar] [CrossRef]
- Tong, S.Y.; Davis, J.S.; Eichenberger, E.; Holland, T.L.; Fowler, V.G., Jr. Staphylococcus aureus infections: Epidemiology, pathophysiology, clinical manifestations, and management. Clin. Microbiol. Rev. 2015, 28, 603–661. [Google Scholar] [CrossRef]
- Staphylococcus aureus Basics. Available online: https://www.cdc.gov/staphylococcus-aureus/about/ (accessed on 1 January 2025).
- Lee, B.Y.; Singh, A.; David, M.Z.; Bartsch, S.M.; Slayton, R.B.; Huang, S.S.; Zimmer, S.M.; Potter, M.A.; Macal, C.M.; Lauderdale, D.S.; et al. The economic burden of community-associated methicillin-resistant Staphylococcus aureus (CA-MRSA). Clin. Microbiol. Infect. 2013, 19, 528–536. [Google Scholar] [CrossRef]
- Zhou, S.; Hokugo, A.; McClendon, M.; Zhang, Z.; Bakshi, R.; Wang, L.; Segovia, L.A.; Rezzadeh, K.; Stupp, S.I.; Jarrahy, R. Bioactive peptide amphiphile nanofiber gels enhance burn wound healing. Burns 2019, 45, 1112–1121. [Google Scholar] [CrossRef]
- Andrabi, S.M.; Majumder, S.; Gupta, K.C.; Kumar, A. Dextran based amphiphilic nano-hybrid hydrogel system incorporated with curcumin and cerium oxide nanoparticles for wound healing. Colloids Surf. B Biointerfaces 2020, 195, 111263. [Google Scholar] [CrossRef]
- Shi, Y.; Zhou, M.; Zhao, S.; Li, H.; Wang, W.; Cheng, J.; Jin, L.; Wang, Y. Janus amphiphilic nanofiber membranes synergistically drive antibacterial and anti-inflammatory strategies for skin wound healing. Mater. Des. 2023, 227, 111778. [Google Scholar] [CrossRef]
- Kang, H.J.; Chen, N.; Dash, B.C.; Hsia, H.C.; Berthiaume, F. Self-Assembled Nanomaterials for Chronic Skin Wound Healing. Adv. Wound Care 2021, 10, 221–233. [Google Scholar] [CrossRef]
- Li, Z.; Zhang, J.; Fu, Y.; Yang, L.; Zhu, F.; Liu, X.; Gu, Z.; Li, Y. Antioxidant shape amphiphiles for accelerated wound healing. J. Mater. Chem. B 2020, 8, 7018–7023. [Google Scholar] [CrossRef]
- Guan, T.; Li, J.; Chen, C.; Liu, Y. Self-Assembling Peptide-Based Hydrogels for Wound Tissue Repair. Adv. Sci. 2022, 9, e2104165. [Google Scholar] [CrossRef] [PubMed]
- Zhu, J.; Tian, J.; Yang, C.; Chen, J.; Wu, L.; Fan, M.; Cai, X. L-Arg-Rich Amphiphilic Dendritic Peptide as a Versatile NO Donor for NO/Photodynamic Synergistic Treatment of Bacterial Infections and Promoting Wound Healing. Small 2021, 17, e2101495. [Google Scholar] [CrossRef] [PubMed]
- Guo, S.; Dipietro, L.A. Factors affecting wound healing. J. Dent. Res. 2010, 89, 219–229. [Google Scholar] [CrossRef] [PubMed]
- Wu, Z.L.; Gong, J.P. Hydrogels with self-assembling ordered structures and their functions. NPG Asia Mater. 2011, 3, 57–64. [Google Scholar] [CrossRef]
- Nichifor, M. Role of Hydrophobic Associations in Self-Healing Hydrogels Based on Amphiphilic Polysaccharides. Polymers 2023, 15, 1065. [Google Scholar] [CrossRef]
- Sun, H.; Fu, X.; Yang, C.; Yuan, C.; Yan, X. Self-assembled amphiphilic peptide hydrogels for antimicrobial application. Curr. Opin. Colloid. Interface Sci. 2024, 73, 101828. [Google Scholar] [CrossRef]
- Rivas, M.; Del Valle, L.J.; Aleman, C.; Puiggali, J. Peptide Self-Assembly into Hydrogels for Biomedical Applications Related to Hydroxyapatite. Gels 2019, 5, 14. [Google Scholar] [CrossRef]
- Findlay, B.; Zhanel, G.G.; Schweizer, F. Cationic amphiphiles, a new generation of antimicrobials inspired by the natural antimicrobial peptide scaffold. Antimicrob. Agents Chemother. 2010, 54, 4049–4058. [Google Scholar] [CrossRef]
- Rahman, M.A.; Bam, M.; Luat, E.; Jui, M.S.; Ganewatta, M.S.; Shokfai, T.; Nagarkatti, M.; Decho, A.W.; Tang, C. Macromolecular-clustered facial amphiphilic antimicrobials. Nat. Commun. 2018, 9, 5231. [Google Scholar] [CrossRef]
- Zhang, N.; Dhumal, D.; Kuo, S.H.; Lew, S.Q.; Patil, P.D.; Taher, R.; Vaidya, S.; Galanakou, C.; Elkihel, A.; Oh, M.W.; et al. Targeting the phosphatidylglycerol lipid: An amphiphilic dendrimer as a promising antibacterial candidate. Sci. Adv. 2024, 10, eadn8117. [Google Scholar] [CrossRef]
- Lei, J.; Sun, L.; Huang, S.; Zhu, C.; Li, P.; He, J.; Mackey, V.; Coy, D.H.; He, Q. The antimicrobial peptides and their potential clinical applications. Am. J. Transl. Res. 2019, 11, 3919–3931. [Google Scholar] [PubMed]
- Qiu, H.; Si, Z.; Luo, Y.; Feng, P.; Wu, X.; Hou, W.; Zhu, Y.; Chan-Park, M.B.; Xu, L.; Huang, D. The Mechanisms and the Applications of Antibacterial Polymers in Surface Modification on Medical Devices. Front. Bioeng. Biotechnol. 2020, 8, 910. [Google Scholar] [CrossRef] [PubMed]
- Liang, Y.; Zhang, Y.; Huang, Y.; Xu, C.; Chen, J.; Zhang, X.; Huang, B.; Gan, Z.; Dong, X.; Huang, S.; et al. Helicity-directed recognition of bacterial phospholipid via radially amphiphilic antimicrobial peptides. Sci. Adv. 2024, 10, eadn9435. [Google Scholar] [CrossRef] [PubMed]
- Henriques, S.T.; Melo, M.N.; Castanho, M.A. Cell-penetrating peptides and antimicrobial peptides: How different are they? Biochem. J. 2006, 399, 1–7. [Google Scholar] [CrossRef]
- Honciuc, A. Amphiphilic Janus Particles at Interfaces. In Flowing Matter; Toschi, F., Sega, M., Eds.; Soft and Biological Matter; Springer: Cham, Switzerland, 2019. [Google Scholar]
- Baravkar, S.B.; Lu, Y.; Masoud, A.R.; Zhao, Q.; He, J.; Hong, S. Development of a Novel Covalently Bonded Conjugate of Caprylic Acid Tripeptide (Isoleucine-Leucine-Aspartic Acid) for Wound-Compatible and Injectable Hydrogel to Accelerate Healing. Biomolecules 2024, 14, 94. [Google Scholar] [CrossRef]
- Hong, S.; Baravkar, S.B.; Lu, Y. Amphiphilic Conjugates of Fatty Acids or their Derivatives. U.S. Patent 63617303, 3 January 2024. [Google Scholar]
- Kisselev, A.F.; Akopian, T.N.; Goldberg, A.L. Range of sizes of peptide products generated during degradation of different proteins by archaeal proteasomes. J. Biol. Chem. 1998, 273, 1982–1989. [Google Scholar] [CrossRef]
- Di, L. Strategic approaches to optimizing peptide ADME properties. AAPS J. 2015, 17, 134–143. [Google Scholar] [CrossRef]
- Tenidis, K.; Waldner, M.; Bernhagen, J.; Fischle, W.; Bergmann, M.; Weber, M.; Merkle, M.L.; Voelter, W.; Brunner, H.; Kapurniotu, A. Identification of a penta- and hexapeptide of islet amyloid polypeptide (IAPP) with amyloidogenic and cytotoxic properties. J. Mol. Biol. 2000, 295, 1055–1071. [Google Scholar] [CrossRef]
- Reches, M.; Porat, Y.; Gazit, E. Amyloid fibril formation by pentapeptide and tetrapeptide fragments of human calcitonin. J. Biol. Chem. 2002, 277, 35475–35480. [Google Scholar] [CrossRef]
- Hsieh, M.C.; Liang, C.; Mehta, A.K.; Lynn, D.G.; Grover, M.A. Multistep Conformation Selection in Amyloid Assembly. J. Am. Chem. Soc. 2017, 139, 17007–17010. [Google Scholar] [CrossRef]
- Pappas, C.G.; Shafi, R.; Sasselli, I.R.; Siccardi, H.; Wang, T.; Narang, V.; Abzalimov, R.; Wijerathne, N.; Ulijn, R.V. Dynamic peptide libraries for the discovery of supramolecular nanomaterials. Nat. Nanotechnol. 2016, 11, 960–967. [Google Scholar] [CrossRef] [PubMed]
- Li, S.; Yu, Q.; Li, H.; Chen, M.; Jin, Y.; Liu, D. Self-Assembled Peptide Hydrogels in Regenerative Medicine. Gels 2023, 9, 653. [Google Scholar] [CrossRef] [PubMed]
- Nelson, D.L.; Cox, M.C. Lehninger: Principles of Biochemistry, 4th ed.; Cell Biochemistry & Function; W.H. Freeman & Co.: New York, NY, USA, 2004. [Google Scholar]
- Kuo, S.H.; Shen, C.J.; Shen, C.F.; Cheng, C.M. Role of pH Value in Clinically Relevant Diagnosis. Diagnostics 2020, 10, 107. [Google Scholar] [CrossRef] [PubMed]
- Sim, P.; Strudwick, X.L.; Song, Y.; Cowin, A.J.; Garg, S. Influence of Acidic pH on Wound Healing In Vivo: A Novel Perspective for Wound Treatment. Int. J. Mol. Sci. 2022, 23, 13655. [Google Scholar] [CrossRef]
- Jones, E.M.; Cochrane, C.A.; Percival, S.L. The Effect of pH on the Extracellular Matrix and Biofilms. Adv. Wound Care 2015, 4, 431–439. [Google Scholar] [CrossRef]
- Schneider, L.A.; Korber, A.; Grabbe, S.; Dissemond, J. Influence of pH on wound-healing: A new perspective for wound-therapy? Arch. Dermatol. Res. 2007, 298, 413–420. [Google Scholar] [CrossRef]
- Owen, S.C.; Shoichet, M.S. Design of three-dimensional biomimetic scaffolds. J. Biomed. Mater. Res. A 2010, 94, 1321–1331. [Google Scholar] [CrossRef]
- Wang, Y.; Mithieux, S.M.; Kong, Y.; Wang, X.Q.; Chong, C.; Fathi, A.; Dehghani, F.; Panas, E.; Kemnitzer, J.; Daniels, R.; et al. Tropoelastin incorporation into a dermal regeneration template promotes wound angiogenesis. Adv. Heal. Mater. 2015, 4, 577–584. [Google Scholar] [CrossRef]
- Mezger, T.G. The Rheology Handbook: For Users of Rotational and Oscillatory Rheometers, 2nd ed.; Vincentz Network GmbH & Co. KG: Hannover, Germany, 2006. [Google Scholar]
- Chen, S.Q.; Liao, Q.; Meldrum, O.W.; Guo, L.; Wang, K.; Zhang, S.; Liu, Y.; Chen, X.; Zhu, J.; Li, L. Mechanical properties and wound healing potential of bacterial cellulose-xyloglucan-dextran hydrogels. Carbohydr. Polym. 2023, 321, 121268. [Google Scholar] [CrossRef]
- Engler, A.J.; Sen, S.; Sweeney, H.L.; Discher, D.E. Matrix elasticity directs stem cell lineage specification. Cell 2006, 126, 677–689. [Google Scholar] [CrossRef]
- Reithofer, M.R.; Chan, K.; Lakshmanan, A.; Lam, D.H.; Mishra, A.; Gopalan, B.; Joshi, M.; Wanga, S.; Hauser, C.A.E. Ligation of anti-cancer drugs to self-assembling ultrashort peptides by click chemistry for localized therapy. Chem. Sci. 2014, 5, 625–630. [Google Scholar] [CrossRef]
- Zhu, J.; Han, H.; Ye, T.T.; Li, F.X.; Wang, X.L.; Yu, J.Y.; Wu, D.Q. Biodegradable and pH Sensitive Peptide Based Hydrogel as Controlled Release System for Antibacterial Wound Dressing Application. Molecules 2018, 23, 3383. [Google Scholar] [CrossRef] [PubMed]
- Sathaye, S.; Zhang, H.; Sonmez, C.; Schneider, J.P.; MacDermaid, C.M.; Von Bargen, C.D.; Saven, J.G.; Pochan, D.J. Engineering complementary hydrophobic interactions to control beta-hairpin peptide self-assembly, network branching, and hydrogel properties. Biomacromolecules 2014, 15, 3891–3900. [Google Scholar] [CrossRef] [PubMed]
- Panahi, Y.; Gharekhani, A.; Hamishehkar, H.; Zakeri-Milani, P.; Gharekhani, H. Stomach-Specific Drug Delivery of Clarithromycin Using a Semi Interpenetrating Polymeric Network Hydrogel Made of Montmorillonite and Chitosan: Synthesis, Characterization and In Vitro Drug Release Study. Adv. Pharm. Bull. 2019, 9, 159–173. [Google Scholar] [CrossRef] [PubMed]
- Salah, N.M.; Saafan, A.E.; Salem, E.H.; El Rabey, H.A.; Alsieni, M.A.; Alatawi, F.A.; Alalawy, A.I.; Abeer Mohammed, A.B. Inhibition of the Vancomycin Resistance in Staphylococcus aureus in Egypt Using Silver Nanoparticles. BioMed Res. Int. 2022, 2022, 7380147. [Google Scholar] [CrossRef]

| Comp# | Structure and Sequence (a) | MS/MS Ions, m/z (b) | Able to Hydro Gelate? (c) | Gelation Time, Min (d) |
|---|---|---|---|---|
| 1 | ![]() hdaa-ILD-NH2 | 527 [M − H+], 509, 412, 394, 242, 224, 207, 165, 131, 114 | yes | 12.3 ± 1.8 |
| p < 0.001 vs. #2; | ||||
| p < 0.05 vs. #3; | ||||
| p < 0.05 vs. #4; | ||||
| p < 0.001 vs. #6 | ||||
| 2 | ![]() 3-hydroxyl decanoic acid-ILD-NH2 | 527 [M − H+], 509, 399, 284, 266 | yes | 30.4 ± 3.8 |
| p < 0.001 vs. #3 | ||||
| p < 0.01 vs. #4 | ||||
| 3 | ![]() hda-ILD-NH2 | 525 [M − H+]. 507, 410, 392, 357, 242, 224, 207, 165, 131, 114 | yes | 5.1 ± 1.0 |
| p < 0.001 vs. #4; | ||||
| p < 0.001 vs. #6 | ||||
| 4 | ![]() 12-hydroxyl dodecanoic acid-ILD-NH2 | 555 [M − H+], 537, 438, 423, 327, 282 | yes | 20.2 ± 2.9 |
| p < 0.01 vs. #6 | ||||
| 5 | ![]() 12-hydroxyl octadecanoic acid-ILD-NH2 | 639 [M − H+], 621, 524, 506, 394, 298 | Not | Infinite |
| 6 | ![]() hdaa-ILK-NH2 | 542 [M + H+], 524, 372, 171, 284, 259, 397, 146 | yes | 30.4 ± 2.6 |
Disclaimer/Publisher’s Note: The statements, opinions and data contained in all publications are solely those of the individual author(s) and contributor(s) and not of MDPI and/or the editor(s). MDPI and/or the editor(s) disclaim responsibility for any injury to people or property resulting from any ideas, methods, instructions or products referred to in the content. |
© 2025 by the authors. Licensee MDPI, Basel, Switzerland. This article is an open access article distributed under the terms and conditions of the Creative Commons Attribution (CC BY) license (https://creativecommons.org/licenses/by/4.0/).
Share and Cite
Hong, S.; Baravkar, S.B.; Lu, Y.; Masoud, A.-R.; Zhao, Q.; Zhou, W. Molecular Modification of Queen Bee Acid and 10-Hydroxydecanoic Acid with Specific Tripeptides: Rational Design, Organic Synthesis, and Assessment for Prohealing and Antimicrobial Hydrogel Properties. Molecules 2025, 30, 615. https://doi.org/10.3390/molecules30030615
Hong S, Baravkar SB, Lu Y, Masoud A-R, Zhao Q, Zhou W. Molecular Modification of Queen Bee Acid and 10-Hydroxydecanoic Acid with Specific Tripeptides: Rational Design, Organic Synthesis, and Assessment for Prohealing and Antimicrobial Hydrogel Properties. Molecules. 2025; 30(3):615. https://doi.org/10.3390/molecules30030615
Chicago/Turabian StyleHong, Song, Sachin B. Baravkar, Yan Lu, Abdul-Razak Masoud, Qi Zhao, and Weilie Zhou. 2025. "Molecular Modification of Queen Bee Acid and 10-Hydroxydecanoic Acid with Specific Tripeptides: Rational Design, Organic Synthesis, and Assessment for Prohealing and Antimicrobial Hydrogel Properties" Molecules 30, no. 3: 615. https://doi.org/10.3390/molecules30030615
APA StyleHong, S., Baravkar, S. B., Lu, Y., Masoud, A.-R., Zhao, Q., & Zhou, W. (2025). Molecular Modification of Queen Bee Acid and 10-Hydroxydecanoic Acid with Specific Tripeptides: Rational Design, Organic Synthesis, and Assessment for Prohealing and Antimicrobial Hydrogel Properties. Molecules, 30(3), 615. https://doi.org/10.3390/molecules30030615







